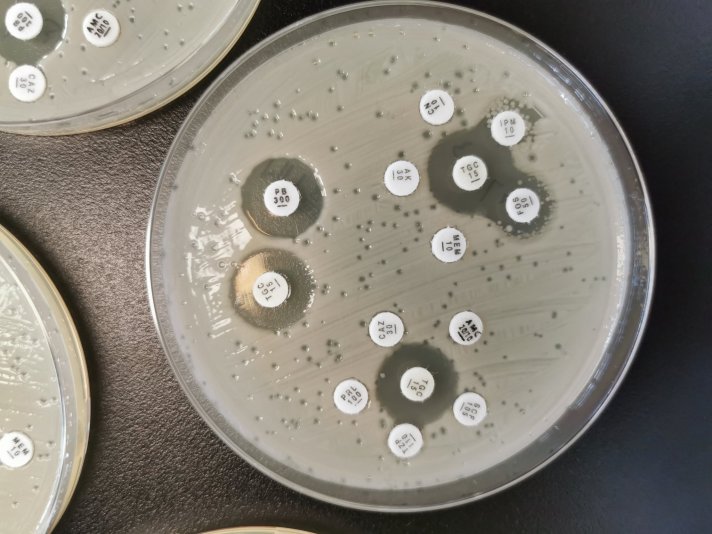

Antibiotic Resistance: Why do we need Phage Therapy?
Are we in a Post-Antibiotic Era?
In daily life, we assume that an infection can be easily treated: We go to the doctor, get some antibiotics and after a while, we feel better. These days, this trust in medicine and drugs, however, may have almost come to an end. Why, after almost a century of success, does the antibiotic era come to an end?
A drug pipeline running dry:
Pharmaceutical companies have developed novel drugs for many decades because bacteria become resistant. However, many major players in the pharmaceutical industry have discontinued their search and development for novel compounds (Loh and Leptihn, 2020). Due to high financial costs for drug discovery and testing and the outlook that the compound will be kept as a so-called reserve antibiotic and not be widely used, most major players in the pharmaceutical industry have abandoned their programs to search and develop novel antibiotics.

Resistant Superbugs:
Bacteria that are resistant to antibiotics are more and more frequent. This is concerning, as simple infections might not be treatable and therefore severe, maybe even lethal. Every time a novel antibiotic drug is introduced, resistance mechanisms quickly arise. We have few choices: Search for the next antibiotic or look for alternatives that do not rely on chemical compounds.
Phage Therapy:
Instead of using chemical antibiotics, phage therapy deploys bacteriophages (Greek for “bacteria eaters”). This bacterial viruses infect and kill bacterial pathogens. Bacteriophages, bacteria and humans co-exist for millions of years, and bacteriophages are beneficial as they protect us. The use of therapeutic phages is safe and phages have several advantages over chemical antibiotics. In our work, we discover phages from the environment that we characterise for their use as biological therapeutics. In addition, we develop synthetic phages that can target specific pathogens to treat incurable infections.

doi: 10.3389/fmicb.2020.01434